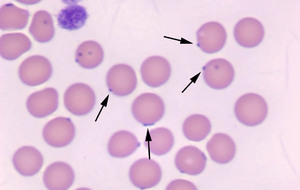
Микоплазмоз у кошек вызывает Mycoplasma felis

Что собой представляет возбудитель болезни?
Микоплазмы – удивительные микроорганизмы, имеющие одно важное отличие от других представителей микрофлоры – отсутствие клеточной оболочки. От внешней среды внутреннюю среду микоплазмы отделяет лишь цитоплазматическая мембрана. И это сближает ее с вирусами. Однако, в отличие от последних, у микоплазмы нее есть и РНК и ДНК. У подавляющего большинства вирусов есть всего одна макромолекула.
Микоплазмы занимают промежуточное положение между вирусами и обычными бактериями. В отличие от классических вирусов микоплазмы, не нуждаются во внутренней среде клеток хозяина для размножения. А от бактерий они отличаются малой генетической памятью, большим разнообразием форм даже в пределах одного вида, различными способами размножения.
Какую опасность представляют микоплазмы?
Микоплазмы – специфические микроорганизмы. Они могут всю жизнь присутствовать в теле носителя и при этом никак не проявлять себя. Поэтому их относят к условно-патогенной микрофлоре.
Микоплазмы – специфические микроорганизмы. Они могут всю жизнь присутствовать в теле носителя и при этом никак не проявлять себя. Поэтому их относят к условно-патогенной микрофлоре.
Более того, совсем недавно ученым удалось обнаружить сразу две новые разновидности микоплазмы, которые ломают стереотипы об этих микроорганизмах.
- Микоплазма-сапрофит. Этот вид микроорганизма питается исключительно разлагающимися тканями.
- Микоплазма-симбионт. В этом случае микроорганизм непросто живет в теле хозяина, но и позитивно влияет на него.
На самом деле, видов микоплазмы очень много и далеко не все из них должным образом изучены. Однако, патогенные виды изучены хорошо.
Мы не станем касаться микоплазмы, которая способна вызывать болезни у человека, а остановимся на вызывающих микоплазмоз у кошек. Речь идет о двух видах:
- Mycoplasma felis.
- Mycoplasma gatae.
Ученые считают эти виды микроорганизмов специфичными. То есть, шансов заразиться ими у человека нет. Впрочем, говорить об этом со стопроцентной уверенностью микробиологи не берутся, поскольку оба вида все еще недостаточно изучены, и то, что случаев инфицирования микоплазмозой кошек человека не зафиксировано, еще ни о чем не говорит.
Главная опасность микоплазмы для кошек заключается в том, что они содержатся в телах 75% всех животных. И каждое такое животное является переносчиком этих микроорганизмов. Микоплазмоз может и не проявиться у конкретной кошки, но она может стать распространителем инфекции. Дело в том, что способов передачи у этого микроорганизма много: алиментарный, половой, контактный, воздушно-капельный.
Причины появления микоплазмоза у кошек
Главная причина возникновения болезни – активация бактерий при возникновении подходящей среды для размножения. Происходит это, как правило, при снижении иммунитета животного.
 Микоплазмы начинают стремительно размножаться, при это вызывают сильную интоксикацию организма носителя продуктами своей жизнедеятельности. Более того, лишенные собственной клеточной оболочки, микоплазмы прикрепляются к клеткам животного и начинают в огромных количествах питательные микроэлементы.
Микоплазмы начинают стремительно размножаться, при это вызывают сильную интоксикацию организма носителя продуктами своей жизнедеятельности. Более того, лишенные собственной клеточной оболочки, микоплазмы прикрепляются к клеткам животного и начинают в огромных количествах питательные микроэлементы.
Вместо них, внутрь клетки поступают вредные вещества, усугубляющие и без того непростое положение кошки. Животное слабеет. У него появляется соответствующая симптоматика.
Признаки микоплазмоза у кошек
Симптомы и лечение этого заболевания тесно взаимосвязаны. Проще говоря, часть лекарственных препаратов назначают с учетом проявившихся симптомов. При микоплазмозе у кошек первыми проявляются следующие симптомы:
- Покраснение склеры и оболочек глаза. В дальнейшем на глазах моет появиться пленка.
- Гнойничковое поражение конъюткивы.
- Респираторные проблемы.
- Лихорадка.
- Диарея.
- У животного отекают лапы.
- Кошка не идет на руки хозяину и может проявлять агрессию.
Если после появления первых симптомов не приступить к лечению, то микоплазмоз у кошки спровоцирует уретрит, цистит и даже может привести к бесплодию. Позднее болезнь начнет разрушать суставы и кости. Микоплазмоз у кошек в запущенной форме всегда приводит к гибели животного.
Диагностика
 Из-за того, что по началу заболевание проявляется неспецифическими симптомами, лечение можно быть назначено только после проведения обследования. Диагноз ставится на основании анализов крови, мазков с конъюнктивы, смывов с ротовой полости и половых органов. К сожалению, ни полимеразная цепная реакция, ни гибридизация РНК, ни аэробные и анаэробные посевы не способны отследить динамику болезни. Эти диагностические методы лишь позволяют выявить микоплазму и определить ее вид.
Из-за того, что по началу заболевание проявляется неспецифическими симптомами, лечение можно быть назначено только после проведения обследования. Диагноз ставится на основании анализов крови, мазков с конъюнктивы, смывов с ротовой полости и половых органов. К сожалению, ни полимеразная цепная реакция, ни гибридизация РНК, ни аэробные и анаэробные посевы не способны отследить динамику болезни. Эти диагностические методы лишь позволяют выявить микоплазму и определить ее вид.
Опытные ветеринары фотографируют больное животное. Это делается для того, чтобы в дальнейшем определить динамику лечения болезни.
Лечение микоплазмоза у кошек
Терапия при микоплазмозе у кошек имеет некоторые особенности:
- Если у кошки проявляются симптомы острой формы болезни, то назначают Диксоциклин и Левомитицин. Как правило, этого достаточно для того, чтобы питомец выздоровел в течение нескольких дней.
- Если выявляются симптомы хронической формы, то парой лекарств не обойтись. Потребуется комплексная терапия и лечение может затянуться на несколько месяцев.
При хронической форме заболевания назначается следующее лечение:
 Прописываются курсы таких антибиотиков, как: Байтрил, Сумамед, Вильпрофен, Тилозин, Тетрациклин, Пенбекс, Левомицетин.
Прописываются курсы таких антибиотиков, как: Байтрил, Сумамед, Вильпрофен, Тилозин, Тетрациклин, Пенбекс, Левомицетин.- Назначаются лекарственные для стимуляции работы внутренних органов: Карсил, Катазал, Гамавит.
- Кошке дают иммуностимуляторы: Риботан, Циклоферон, Иммунофан.
- Регулярно обрабатывают слизистые оболочки Тетрациклином.
Скорость выздоровления питомца зависит от следующих факторов:
- Точность постановки диагноза.
- Правильность назначенной терапии.
- Уровень иммунитета пациента.
- Качество ухода и питания больной кошки.
Профилактика микоплазмоза у кошек
Ученым до сих пор не удалось создать вакцину против микоплазмоза у кошек, но это вовсе не значит, что питомца нельзя уберечь от этой болезни. В качестве профилактики можно принять следующие меры:
- Обеспечить питомцу качественное и сбалансированное питание.
- Исключить возможность контактов домашней кошки с дворовыми котами.
- Добавить в рацион специальные витамины и препараты для повышения иммунитета.
- Регулярно наблюдаться у ветеринарного врача.
- Отслеживать изменение состояния питомца.
Следует помнить о том, что какие бы профилактические меры ни принимались всегда сохраняется риск заражения питомца. Но придерживаясь вышеописанных мер, можно минимизировать вред здоровью от болезни, если животное ее все же подхватит.


